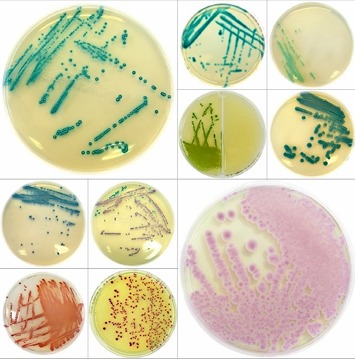
Liofilchem Chromatic Media

Partners Globales
Representamos marcas líderes mundiales para traer la mejor tecnología a Uruguay.

Líder en diagnósticos Point-of-Care (POCT). Seamaty revoluciona la atención médica llevando la precisión de un laboratorio central a cualquier lugar. Dispositivos compactos, fáciles de usar y resultados inmediatos para decisiones críticas.

Desde Italia para el mundo, Liofilchem es sinónimo de excelencia en microbiología. Desarrollamos y producimos sistemas de identificación microbiana y antibiogramas (MIC Test Strip), medios de cultivo cromogénicos y sistemas de enriquecimiento. Calidad certificada ISO 9001 e ISO 13485 para resultados en los que puede confiar.

Biobase ofrece un ecosistema completo de soluciones para laboratorios y aplicaciones médicas. Desde cabinas de bioseguridad hasta analizadores automatizados, garantizamos robustez, seguridad y cumplimiento normativo internacional.